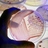
Beth Curtis - @bethcurtis1234 - Twitter

Beth Curtis
Found 292 people in California, Ohio, Alaska and other states


Dr Beth Curtis - @curtis_beth1
FE lecturer, teacher educator, drama teacher, creative methods, creativity. All views my own.

beth curtis - @bessy_curtiss
performer and gin enthusiast with a hatred for deep house buns.


Beth Curtis - @BethCurtis2
Beth Curtis - @bethcurtis1234

Beth Curtis - @Bethhughes19862
Cambridgeshire life with my husband and pets.

Beth Curtis - @OTBPLYM
27, occupational therapist working in mental health. Passionate about the mind, holistic health and nutrition. Love for blue space, movement and self-care💧

Beth Curtis - @auntbeth1979

Curtis Beth - @Beth3Curtis
Love people and fun! (And warm sunny days 😀)
Sponsored by SpokeoPaid Service
Beth E Curtis
S*****@gmail.com — (614) 372-****
*****b Mcdermott Rushtown Rd, Mc Dermott, OH
View full reportBeth A Curtis
D*****@hotmail.com — (812) 736-****
***** N Maple Ct, Ellettsville, IN
View full reportBeth A Curtis
(330) 792-****
***** Onondaga Ave, Lakewood, OH
Sponsored by PeopleLookerPaid Service
(931) 224-****
Beth Curtis, Bowling Green, KY
Sponsored by SpokeoPaid Service
Beth Curtis
Sponsored by PeopleLookerPaid Service
Search for contact info, city & state history, relatives, jobs, education & more
Search public records
Beth Curtis 🤍✨ - @bethcurtis98
lifestyle | books | travel | walking
🍵🌞🥰🫶🏻✨
221 followers

Beth Curtis9870 - @bethcurtis06
161 followers

beth.curtis - @beth.curtis5
NE Scotland 🏴 Equestrian life is the best life 🐴
924 followers

Beth Curtis - @bethcurtis85
13 followers

beth.curtis - @beth.curtis
71 followers

Beth Curtis - @bethcurtis8
I'm too old and confused for this
139 followers

Beth Curtis - @bethcurtis23
55 followers

Beth Curtis - @bethanykcurtis
31 Essex
@dot_the_mini_daxie on insta 🐾
166 followers

Beth Curtis - @beth.curtis7
60 followers

Beth Curtis - @bbethcurtis
31 followers

Beth Curtis - @beth.curtis6
42 followers

Beth Curtis - @beth.curtis4
98 followers

Beth. Curtis - @beth..curtis
3 followers

Beth Curtis - @beth.curtis92
6 followers

Basicb226❌ - @bethcurtis4
31 followers

lostcause23 - @bethcurtis883
5 followers

Texas momma 81 - @bethcurtis0
I am a mom of four great kids I love to listen to music and meet new people
693 followers

Beth_Curtis - @beth_curtis
13 followers

bethcurtis94 - @bethcurtis94
6 followers

bethcurtis - @bethcurtis
1 follower

BethCurtis - @bethcurtis2
Funny, free, honest, loving,loyal, and humble. Love me don't change me
31 followers

_bethcurtis - @_bethcurtis
1 follower

bethcurtis878 - @bethcurtis878
62 followers

bethcurtis925 - @bethcurtis925
32 followers

bethcurtiss7 - @bethcurtiss7
13 followers

bethhcurtis - @bethhcurtis
2 followers

Beth Curtiss - @beth.curtiss
16 followers

Beth Curtiss - @bethcurtiss
1 follower
Beth Curtis - @bethcn1
11 subscribers
Beth Curtis - @bethcurtis4777
1 subscriber
Beth Curtis - @bethcurtis9869
3 subscribers
Beth Curtis - @bethcurtis7353
Life for Pot.
Beth Curtis - @bethcurtis8812
1 subscriber
Beth Curtis - @beamaral2
3 subscribers
Beth Curtis - @bethcurtis4466
27 subscribers
beth Curtis - @bethcurtis4518
2 subscribers
Katie-Beth Curtis - @katie-bethcurtis6011
5 subscribers


Beth Curtis
Impact Philanthropy



Dr Beth Curtis
LXI Portfolio Officer, University of Exeter

Beth Curtis
Partner, Langenkamp, Curtis, Price, Lindstrom ...


Beth Curtis
Vice Principal Business Development ...

M. Beth Curtis





Beth Curtis
Occupational Therapist with Select Rehab

Beth Curtis
Owner/Operator at Atomic Genius Records and ...



Beth Curtis
-
East Syracuse-Minoa Central High School (1998 - 2002)
East Syracuse, NY
-
East Syracuse-Minoa Central High School (1998 - 2001)
East Syracuse, NY
Beth Curtis
-
Metropolitan Baptist High School (1998 - 2002)
Madison, TN
Beth Curtis
-
Gresham High School (1998 - 2002)
Gresham, OR
Beth Curtis
-
Forreston High School (1995 - 1999)
Forreston, IL
Beth Curtis
-
Wayne High School (1994 - 1998)
Wayne, WV
Beth Curtis
-
Dr. Phillips High School (1993 - 1997)
Orlando, FL
Beth Curtis
-
Irondequoit High School (1992 - 1996)
Rochester, NY
Beth Curtis
-
Cardinal Mooney High School (1990 - 1994)
Youngstown, OH
Beth Curtis
-
Henry Ford High School (1987 - 1991)
Detroit, MI
Beth Curtis
-
Atchison County Community High School (1986 - 1990)
Effingham, KS
Beth Curtis
-
Meridian High School (1985 - 1989)
Meridian, MS
Beth Curtis
-
Hermiston High School (1985 - 1989)
Hermiston, OR
Beth Curtis
-
Cabrillo High School (1985 - 1989)
Lompoc, CA
Beth Curtis
-
Shrewsbury High School (1985 - 1988)
Shrewsbury, MA
Beth Curtis
-
Ponderosa High School (1984 - 1988)
Parker, CO
Beth Curtis
-
Lake Braddock Secondary School (1982 - 1986)
Burke, VA
Beth Curtis
-
Bishop Kenny High School (1979 - 1983)
Jacksonville, FL
Beth Curtis
-
Bradford High School (1977 - 1981)
Kenosha, WI
Beth Curtis
-
Miami Carol City High School (1974 - 1978)
Opa Locka, FL
Beth Curtis
-
Southwest High School (1974 - 1978)
Green Bay, WI
Beth Curtis
-
Pike Central High School (1974 - 1976)
Petersburg, IN
-
Winslow High School (1972 - 1974)
Winslow, IN
-
Winslow Elementary School (1964 - 1972)
Winslow, IN
Beth Curtis
-
Tullahoma High School (1971 - 1975)
Tullahoma, TN
Beth Curtis
-
Merrillville High School (1970 - 1974)
Merrillville, IN
Beth Curtis
-
Fairhope High School (1960 - 1964)
Fairhope, AL
Elizabeth Curtis
-
Lewis County High School (2015 - 2019)
Hohenwald, TN
Elizabeth Curtis
-
Karl G. Maeser Preparatory Academy (2008 - 2012)
Lindon, UT
Elizabeth Curtis
-
Covert High School (2006 - 2010)
Covert, MI
Betty Curtis
-
Jay High School (2001 - 2005)
Jay, OK
Lizzie Curtis
-
Dolgeville Central High School (2000 - 2004)
Dolgeville, NY
Liz Curtis
-
Lincoln Elementary School (1999 - 2003)
Ottawa, IL
Elizabeth Curtis
-
Northwood High School (1997 - 2001)
Northwood, OH
Betsy Curtis
-
North Canyon High School (1997 - 2001)
Phoenix, AZ
Elizabeth Curtis
-
Caldwell High School (1995 - 1999)
Caldwell, OH
Elizabeth Curtis
-
Euclid High School (1995 - 1999)
Euclid, OH
Elizabeth Curtis
-
Wheeler High School (1990 - 1994)
North Stonington, CT
Elizabeth Curtis
-
Brethren High School (1963 - 1987)
Paramount, CA
Elizabeth Curtis
-
Angola High School (1974 - 1978)
Angola, IN
Elizabeth Curtis
-
Central High School (1974 - 1978)
Providence, RI
Betty Curtis
-
Post High School (1973 - 1977)
Post, TX
Elizabeth Curtis
-
Heritage Hall High School (1971 - 1975)
Oklahoma City, OK
Lizzie Curtis
-
Choctaw County High School (1967 - 1971)
Butler, AL
Elizabeth Curtis
-
Minnechaug Regional High School (1967 - 1971)
Wilbraham, MA
Elizabeth Curtis
-
Mary E. Fogarty Elementary School (1964 - 1968)
Providence, RI
Betty Curtis
-
Hastings High School (1964 - 1968)
Hastings, NE
Liz Curtis
-
Mayville Central High School (1963 - 1967)
Mayville, NY
Betty Curtis
-
Cohn High School (1951 - 1955)
Nashville, TN
Betty Curtis
-
Jacksonville High School (1938 - 1942)
Jacksonville, IL
Beth Curtis
Sponsored by PeopleLookerPaid Service
Search for Beth Curtis's city and state history
Search address history

Beth A. Curtis
Died: March 14, 2021 (aged 53)
Born: August 2, 1967

Beth Ann Young Curtis
Died: March 17, 2016 (aged 73)
Born: February 28, 1943



Beth Stout Curtis
Died: September 24, 1975 (aged 82)
Born: August 22, 1893



Websites owned by Beth Curtis
prisonersleftbehind.com
Registered on December 16, 2018
lifeforcannabis.info
Registered on March 28, 2017
lifeforcannabis.org
Registered on March 30, 2017
releasenonviolentdrugoffenders.org
Registered on June 10, 2012
lifeforcannabis.net
Registered on March 28, 2017
lifeforcannabis.com
Registered on March 28, 2017
lifeforpot.com
Registered on August 31, 2010
crossfitcatawbavalley.com
Registered on September 19, 2013
catawbavalleycrossfit.com
Registered on August 17, 2013
potlifers.info
Registered on September 12, 2015
potlifers.net
Registered on September 12, 2015
bethscamino.com
Registered on July 11, 2015
potlifers.org
Registered on September 12, 2015
potlifers.com
Registered on September 12, 2015
lifersforpot.com
Registered on September 4, 2015
lifersforpot.info
Registered on September 4, 2015
lifersforpot.net
Registered on September 4, 2015
lifersforpot.org
Registered on September 4, 2015
lwop.org
Registered on September 11, 2014
lwop.net
Registered on September 11, 2014
lifewithoutparole.org
Registered on September 11, 2014
lifewithoutparole.net
Registered on September 11, 2014
Reverend Beth Eileen Curtis Obituary February 16, 2025
Munden Funeral Home - Sun, 16 Feb 2025
Obituary for Beth (Sprinkle) Curtis
jobefuneralhome.com - Tue, 27 Jun 2023
Jon Evans Obituary Mansfield, OH
Dignity Memorial - Sun, 01 Jun 2025
Obituary for Beth Curtis
Karvonen Funeral & Cremation Service - Sat, 12 Jun 2021
Late (but great!) Start
Idaho State University - Wed, 01 Nov 2023
Beth Curtis Keenan Obituary Pacific Grove, CA
Monterey Herald - Tue, 04 Jun 2024
Beth Curtis moved to San Francisco after college
Rockton-Roscoe News - Tue, 18 Jun 2024
'It's time for Tuscaloosa to catch up': Leaders form group to boost school funding
The Tuscaloosa News - Tue, 27 Aug 2024
Linda Lou Curtis
Coulee Region Cremation Group - Fri, 21 Dec 2018
Raymond Curtis Obituary December 18, 2023
Belton Stroup Funeral Home - Mon, 18 Dec 2023
Sarah Beth Curtis 9/01/2018
sperrymchoul.com - Sat, 01 Sep 2018
Tala Curtis
AL.com - Tue, 14 Jun 2022
UA Inducts 5 into Educator Hall of Fame
UA News Center - Fri, 23 Feb 2024
MARY CURTIS Obituary (2018) Westlake, OH
Cleveland.com - Fri, 08 Oct 2021
Obituary | Bobby D. Curtis of Murfreesboro, Tennessee
Woodfin Funeral Chapel - Fri, 29 May 2020
In this guest piece, Joy Beth Curtis offers suggestions for mental health care.
Psychology Today - Mon, 18 Jan 2021
A look at the Olympic experience by a former County resident.
WAGM - Mon, 29 Jul 2024
Michael Saletta Obituary (2024) Minoa, NY
Syracuse.com - Wed, 04 Sep 2024
British expat finds niche in Zanzibar tourism business after working in VIP hospitality
thecitizen.co.tz - Fri, 28 Feb 2025
PHOTOS: Retiring Verner Principal Honored
The Tuscaloosa News - Fri, 15 May 2020
Carol Zuber Obituary December 30, 2024
Dooley Funeral Home - Mon, 30 Dec 2024
Newly discovered Edward Curtis Alaskan photos on display at Muskegon Museum of Art
FOX 17 West Michigan News - Mon, 06 Sep 2021
Tala Curtis Obituary
The Tuscaloosa News - Sun, 19 Jun 2022
Kay Louise Curtis Griffin Obituary September 17, 2024
Munden Funeral Home - Tue, 17 Sep 2024
Annelizabeth Curtis Obituary April 17, 2014
New Comer Cremations & Funerals - Thu, 17 Apr 2014
California school district near Nevada caught up in a dispute over transgender athlete policies
WPLG Local 10 - Fri, 19 Dec 2025
Midland Public Schools recognizes exceptional teachers, support staff members
Midland Daily News - Wed, 17 Aug 2022
Carolyn Barger Obituary Ontario, OH
Dignity Memorial - Sat, 10 Aug 2024
Larry G. Curtis Obituary 09/30/2013
Dillow-Taylor Funeral Home - Mon, 30 Sep 2013
Death notices for the Stateline: June 24, 2024
Rockton-Roscoe News - Mon, 24 Jun 2024
Joanne Curtis Obituary September 10, 2015
Mortensen Funeral Homes - Thu, 10 Sep 2015
Shirley Anne Curtis Obituary (1937 2025) Clinton, NY WKTV
Legacy | Obituary - Mon, 27 Oct 2025
Lifeguard honored for saving boy's life last summer
The Columbus Dispatch - Thu, 01 Jan 2015
Mark Smith Obituary Springfield, IL
Dignity Memorial - Sat, 21 Aug 2021
Leatha Curtis Obituary (2023) Midland, MI Midland Daily News
Legacy | Obituary - Thu, 14 Sep 2023
Adams Elementary students show off roller coasters
Midland Daily News - Tue, 12 Feb 2013
Evert Raymond Curtis Sr.
Legacy | Obituary - Wed, 22 Nov 2023
Outside Trump’s Inner Circle, Odds Are Long for Getting Clemency (Published 2020)
The New York Times - Tue, 29 Dec 2020
Verner Elementary School
The Tuscaloosa News - Sun, 26 Jul 2009
Oscar Curtis Obituary (1930 2015) East Palestine, OH Pittsburgh Tribune Review
Legacy | Obituary - Tue, 13 Jun 2023
Randall Curtis Obituary (2024) Tompkinsville, KY Yokley-Trible Funeral Home
Legacy | Obituary - Tue, 16 Jul 2024
Raymond F. Curtis Sr. Obituary (2023) Clinton, NY Heintz Funeral Service Inc. Herkimer Rd. Location
Legacy | Obituary - Tue, 24 Jan 2023
Richard Curtis Obituary (2022) Olean, NY Olean Times Herald
Legacy | Obituary - Fri, 15 Apr 2022
Brenda Foley Obituary (1962 2020) McDonald, PA Observer-Reporter
Legacy | Obituary - Fri, 03 Jul 2020
Life in prison for pot? As laws ease, some remain behind bars without parole, for non-violent pot crimes
CBS News - Tue, 11 Mar 2014
Naomi Britton Obituary (2010) Lynn, Norfolk Lynn News
Legacy | Obituary - Fri, 25 Jun 2010
Janet Wooten Obituary Mansfield, OH
Dignity Memorial - Sun, 25 Jul 2004
Minister and employers welcome progress by Local Skills Improvement Plan
The Hull Story - Tue, 24 Sep 2024
Work starts on new animal care centre at Grimsby Institute
Grimsby Live - Thu, 11 Jan 2024
beth curtis-clarke - @bcc180281
304 photos - 2 followers
Katie Beth Curtis - @kbonly4him
86 photos - 0 followers
Beth Curtis - @bethc1974
0 photos - 0 followers
beth curtis - @bethc213
0 photos - 0 followers
Beth Curtis - @wcxcggrt48
0 photos - 0 followers
Beth Curtis - @BethandMike3019
0 photos - 1 follower
Beth Curtis-Clarke - @bethcurtisclarke
0 photos - 0 followers
Beth Curtis - @elizabeth.curtis18
0 photos - 1 follower
Beth Curtis-Clarke - @bcurtisclarke
0 photos - 0 followers
Beth Curtis - @betty06ish
0 photos - 0 followers
Beth Curtis - @Beth Curtis
0 photos - 1 follower
beth curtis - @mrs_jacob_black
0 photos - 1 follower
Beth Curtis - @bcurtis544
0 photos - 0 followers
Beth Curtis - @curtis.beth10
0 photos - 0 followers

Melinda Beth Curtis - @mbcurtis
11,126 followers

Sarah Beth Curtis 📷 - @sarahbcurtis78
954 followers

Beth Curtis - @bethmcurtis
552 followers

Beth Curtis - @10chun
123 followers

Beth Curtis - @bethcurtis600
0 followers

Beth Beers Curtis - @mimibeth
179 followers

Beth Curtis - @bc1974
366 followers

Beth Curtis - @bethereth
78 followers

Beth Curtis - @bcurtis97
314 followers

Beth Curtis - @3beth
190 followers

Beth Curtis - @bethjanecurtis
253 followers

Beth Curtis - @biffrack
85 followers

Beth Curtis - @dcurtis24
39 followers

Beth Cowell Curtis - @bethc422
123 followers

Beth Curtis - @biffrack2362
0 followers

Beth Curtis - @bcurtis1045
0 followers

Beth Curtis - @beth5curtis
0 followers

Beth Curtis - @bethcurtis354
0 followers

Beth Curtis - @bethcurtis811
0 followers

Beth Curtis - @mrsstevecurtis
0 followers

Beth Curtis - @bcurtis2661
0 followers

Mary Beth Curtis - @mbcurtis88
0 followers

Beth Curtis - @bcurtis0187
0 followers

Beth Curtis - @bcurtis262
0 followers

beth curtis - @bethndavecurtis
0 followers

Beth Curtis - @bcurtis3582
0 followers

Beth Curtis - @bethcurtis235
0 followers

Beth Curtis - @bcurtis2425
0 followers

Beth Curtis - @auntbeth1979
0 followers

Beth Curtis - @lizb113
103 followers

Beth Curtis - @bethcurtis62
96 followers

Beth Curtis - @bcurtis06
100 followers

Beth Curtis - @bethycurtis
111 followers

Beth Curtis - @mbcurtis8
2 followers

Beth Curtis - @bethcurtis0430
35 followers

Beth Curtis - @bcurtisxxx
0 followers

Beth Curtis - @foreverwomack
0 followers

Beth Curtis Cole - @bcurtiscole
0 followers

Beth Curtis - @bcurtis0136
0 followers

Lesley Beth Curtis - @lesleybethcurti
0 followers

Beth Curtis - @bethcurtis1226
0 followers

Beth Curtis - @baton4611
0 followers

Beth Curtis - @bethwait60
0 followers

Beth Curtis - @bethcurtis790
0 followers

Beth Curtis - @becurtisfcps
0 followers

Beth Curtis - @bcpinetree
0 followers

Beth Rice Curtis - @maggieliz1960
0 followers

Beth Curtis - @red2blond2002
0 followers

beth curtis - @moosembc
0 followers

beth curtis - @bfcurtis1522
0 followers

Beth Curtis
64 followers

Beth Curtis
MA in psychology from Medaille College
18 followers

Beth Curtis
Lives in Carthage, Tennessee
45 followers

Beth Curtis
Lives in Huntly, Aberdeenshire
9 followers

Beth Curtis
16 followers

Beth Curtis
Works at Emirates Airlines
12 followers

Beth Curtis
9 followers

Beth Curtis
Lives in Hampton, VA
9 followers

Beth Curtis
6 followers

Beth Curtis
B.Tech civil engineering from Osmania University (2015)
2 followers

Merrillvue (1973)
Lake County Public Library
1973

Maple Trail
Rachel Roberts and William McConnell, Co-editors; Thomas V. Jeffries, Advisor
1978

Merrillvue (1974)
Lake County Public Library
1974

Lowellian (2002)
Lake County Public Library
2002

Surveyor
Mount Vernon High School
1980

Colonial : Shrewsbury High School yearbook
Shrewsbury High School (Mass.)
1986

Lowellian (2001)
Lake County Public Library
2001

Edwardsville High School Tiger Yearbook 1986
Edwardsville High School
1986

1982 Eastern Hancock High School Yearbook
Eastern Hancock High School
1982

1986 Badin Catholic High School Yearbook
Badin Catholic High School
1986

Midlander
1959

1988 Culpeper County High School Yearbook
Culpeper County High School
1988

The Howler
Wake Forest University
1984

Lowellian (2000)
Lake County Public Library
2000

Matador
John Trotwood Moore Junior High School (Nashville, Tenn.)
1972

Grafton High School yearbook
Grafton High School (Grafton, Mass.)
1979

1969 Winslow High School Yearbook
Winslow High School
1969
Lesley Beth Curtis - Sacramento
Lesley Beth Curtis practices labor and employment law on behalf of unions and employees, and specializes in plaintiff-side labor, employment and education law.
Beth Curtis - IMDb
Beth Curtis. Actress: The Grave. Beth Curtis is known for The Grave (1996), The Addiction (1995) and The Funeral (1996).
Beth Curtis, MA - Gavia LifeCare Center LLC
Beth Curtis, MA. Clinical Director. Brief info. Beth (she/her) is a Clinical Director for adult clients at Gavia LifeCare ...
beth curtis - Last Prisoner Project
Beth Curtis is the founder of Life for Pot & Release Nonviolent Drug Offenders. She earner her MSW from Ohio State University.
Beth Curtis | CASE
Beth Curtis is a development professional with experience in corporate and foundation relations, annual campaign fundraising, major gifts, endowment and ...
Lessons from a Leader: Beth Curtis | Opinion | southsoundbiz.com
Beth Curtis always has been fond of the music and arts scene. That's why, when the chance to open Atomic Genius Records in Puyallup ...
Cheers (TV Series 1982–1993) - Amanda Wyss as Beth, Beth Curtis
Cheers (TV Series 1982–1993) - Amanda Wyss as Beth, Beth Curtis.
Reverend Beth Eileen Curtis Obituary February 16, 2025
... beth-curtis. OR. Open In Email Client · Send Flowers · Plant A Tree · Send a Gift. Reverend Beth Eileen Curtis ...
Elizabeth Curtis - College of Education - The University of Alabama
Beth Curtis completed her B.S.E. in 1970 in elementary education at the Capstone. She has served as an educator for more than 50 years and has taught ...
Beth Curtis | Owner, Atomic Genius Records - Women in Vinyl
Meet Beth Curtis, the Owner / Operator of Atomic Genius Records & More, a small independent brick and mortar store located in downtown Puyallup, Washington.
Beth Curtis | Cheers Wiki - Fandom
Beth Curtis is Woody's ex-girlfriend from Woody Goes Belly Up.
Beth Curtis - Brentwood Baptist
Staff. Home Staff Beth Curtis. Beth Curtis. Groups Administrative Assistant. bcurtis@brentwoodbaptist.com · Back to All Staff. Contact Us. (615) 324-6100 · info ...
Beth Curtis (@bethcurtis62) • Threads, Say more
Beth Curtis. bethcurtis62. threads.net. bethcurtis62's profile picture. Wife, mom, quilter, knitter, love sports-- Go Giants! Roll Tide! Let's Go Mets! 190 ...
Beth Curtis moved to San Francisco after college
Beth Curtis moved to San Francisco after college ... A private family memorial will be held July 5, 2024. Michael McGinnis. Jun 18, 2024 ...
Obituary for Beth (Sprinkle) Curtis | Jobe Funeral Home & Crematory ...
Beth Curtis Obituary. Beth Eileen (Sprinkle) Curtis, 65, of Delmont, passed away on Tuesday, June 27, 2023. She was born on February 9, 1958 ...
Beth Curtis, former ACF in Rheumatology - University of Southampton
My NIHR ACF has given me the opportunity to...feel as though I am making a contribution towards improving human health for the future. Dr Beth Curtis - ACF in ...
Letter from Beth Curtis Magnuson to Harriet Leitch, August 26, 1948
Letter from Beth Curtis Magnuson, Edward S. Curtis' daughter, responding to Harriet Leitch's inquires about her father. She informs Ms. Leitch that her father ...
Beth Curtis — The Movie Database (TMDB)
Beth Curtis is known as an Art Direction. Some of their work includes The Addiction, The Funeral, and A Stranger in the Kingdom.
431 Beth Curtis Stock Photos, High-Res Pictures, and Images
Explore Authentic Beth Curtis Stock Photos & Images For Your Project Or Campaign. Less Searching, More Finding With Getty Images.
Dr Elizabeth Curtis - Bone Research Society
Beth Curtis is an Associate Professor in Rheumatology and Honorary Consultant Rheumatologist at the MRC Lifecourse Epidemiology Centre, University of ...
Beth Curtis: Age, Phone Numbers, Address - Veripages
Beth Curtis's date of birth is September 1950. Beth Curtis is 74 years old. Where does Beth Curtis live? Beth Curtis's address is 2242 High Point Dr, The ...





























































































































































